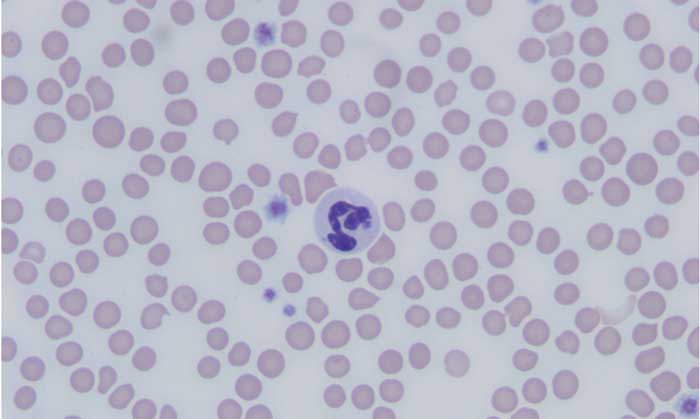

Page 10 < previous page > <next page>
TICKS
Granulocytic Anaplasmosis
Christine Savidge, DVM, DACVIM, Atlantic Veterinary College, Charlottetown, Prince Edward Island
PARASITOLOGY | MARCH 2019 | PEER REVIEWED
Granulocytic anaplasmosis, an acute disease that affects dogs, cats, and other mammals, results from infection with the bacterium Anaplasma phagocytophilum and is transmitted primarily ?? the bite of an Ixodes spp tick.
Exposure is most prominent in areas endemic for Ixodes spp. Most dogs and cats exposed to A phagocytophilum do not develop clinical signs, but animals that do develop clinical disease often show nonspecific signs of lethargy, fever, and decreased appetite.
Although there are several species in the Anaplasmataceae family that can cause anaplasmosis, this article focuses on A phagocytophilum.
Background & Pathophysiology
A phagocytophilum, a gram-negative intracellular bacterium, infects neutrophils and, occasionally, eosinophils in a variety of mammals, including dogs and cats. Although the organism is primarily vector-transmitted by the bite of an Ixodes spp tick, transmission via blood transfusion has been described in humans, so dogs and cats that donate blood should be tested for infection prior to donation. Because of the shared Ixodes spp tick vector, concurrent infection with Borrelia burgdorferi has been reported in dogs and cats and may contribute to more severe clinical manifestation than either infection alone.
Geographic distribution of anaplasmosis follows that of the tick vector, and the seroprevalence of A phagocytophilum in dogs and cats varies by region. Anaplasmosis has been reported with highest incidence in the midwest, northeast, and western United States. Infection has also been reported in Canada, Europe, Asia, and South America, although more studies are needed to understand vector transmission in areas not endemic for Ixodes spp.
Risk for exposure and/or infection is increased in animals that live in an Ixodes spp-endemic area, receive acaricidal
medications inconsistently, and have increased outdoor access, particularly to natural tick habitats. Transmission to
mammals occurs within 24 to 48 hours of tick attachment. Disease prevalence corresponds with increased Ixodes spp tick activity and is therefore highest in the late spring and autumn. Seropositive prevalence is increased in older dogs and cats, as these animals have had more years of exposure. Prevalence of exposure to A phagocytophilum and incidence of clinical disease are not equal. Most dogs that test positive for A phagocytophilum infection have no history of clinical illness, and cats that test positive for A phagocytophilum serum antibodies may not have signs of clinical disease. This discordance complicates testing and confirmation of disease.
History
Dogs and cats are often presented within 2 to 3 days (range, 1-14 days) of onset of signs. Acute lethargy, malaise, and decreased appetite are the most common clinical signs on presentation, with signs of lameness, circling, vomiting, and epistaxis reported less commonly. Relevant history includes inconsistent or irregular receipt of antiparasitics or acaricides, travel history, and known tick exposure.
Clinical signs
Clinical presentation is variable and depends on the strain of bacterium and host variables, including immune response and coinfections. Most dogs and cats exposed to A phagocytophilum do not develop disease or develop only mild self-resolving signs, as suggested by experimental infections and high positive serology in the absence of clinical disease. Animals that do develop clinical illness may show a variety of multisystemic, infammatory signs but most commonly show nonspecific signs of lethargy, fever, and decreased appetite. Lameness or muscle pain, lymphadenopathy, splenomegaly, and, more rarely, neurologic signs of circling, seizures, neck pain, and epistaxis have also been reported.
Diagnosis
Making an accurate clinical diagnosis can be challenging, as many dogs and cats that are exposed to A phagocytophilum do not develop clinical disease. Determining whether an animal’s signs are attributable to active infection requires a multimodal approach to diagnosis. Diagnosis of acute granulocytic anaplasmosis should include consistent history and clinical signs, as well as support from CBC results, with direct visual examination of a blood smear, serology testing for specific antibodies, and PCR testing.
The most common abnormalities seen on CBC in dogs are thrombocytopenia, anemia, and leukopenia ; these
changes are also exhibited in cats, although cats are more prone to platelet clumping and should not be erroneously
diagnosed with thrombocytopenia in these cases.
Treatment is Doxycline, 5mg/kg for 14-28 days.
Regular tick preventive use is warranted in animals with outdoor access and animals that live in an Ixodes spp-endemic area, as routine use has been shown to significantly reduce the risk for infection.

New Yorkers brace for self-cloning Asian longhorned tick
Researchers warn that NYC's Asian longhorned tick population is larger than previously known.
March 28, 2019, Columbia University
Summary:
A new study maps out the increase and spread of the Asian longhorned tick, a new species identified last summer in Westchester and Staten island. What's particularly alarming is that the tick is notorious for its ability to quickly clone itself through asexual reproduction, or reproduce sexually, laying 1,000-2,000 eggs at a time.
FULL STORY
The new species, identified last summer in Westchester and Staten island, is increasing and spreading quickly.
Credit: Center for Disease Control and Prevention
Staten Island residents have another reason to apply insect repellent and obsessively check for ticks this spring and summer: the population of a new, potentially dangerous invasive pest known as the Asian longhorned tick has grown dramatically across the borough, according to Columbia University researchers. And the tick -- which unlike other local species can clone itself in large numbers -- is likely to continue its conquest in the months ahead.
"The concern with this tick is that it could transmit human pathogens and make people sick," explains researcher Maria Diuk-Wasser, an associate professor in the Columbia University Department of Ecology, Evolution and Environmental Biology, who studies ticks and human disease risk.
In a new study appearing in the April issue of the journal Emerging Infectious Diseases, Diuk-Wasser and colleagues provide the most exhaustive local census of the new species to date -- and suggest the Staten Island infestation is far more advanced than previously known.
The researchers found the species Haemaphysalis longicornis in 7 of 13 parks surveyed in 2017 and in 16 of 32 in 2018. In one park, the density of the ticks per 1000 square meters rose almost 1,698 percent between 2017 and 2018, with the number of ticks picked up in the sample area rising from 85 to 1,529. They also found the ticks on anesthetized deer from the area.
The news comes less than a year after the New York City Department of Health announced the discovery of the first member of the species in the city -- a single tick -- found on southern Staten Island last August.
The tick, native to Asia and Australia, had been identified in the months prior to the Staten Island sighting in New Jersey, West Virginia, North Carolina and Arkansas and just a few weeks earlier in Westchester County. The Westchester sighting prompted a number of state senators to send a letter urging state health officials to act aggressively to stop the spread of the new species.
Public health officials are particularly concerned because the longhorned tick is notorious for its ability to quickly replicate itself. Unlike deer ticks, the common local variety known for carrying Lyme disease, the female Asian longhorned can copy itself through asexual reproduction in certain environmental conditions, or reproduce sexually, laying 1,000-2,000 eggs at a time. They are typically found in grass in addition to the forested habitats that deer ticks prefer, adding a new complication to public health messaging. The Columbia analysis suggests that the public warnings may have come too late.
"The fact that longhorned tick populations are so high in southern Staten Island will make control of this species extremely difficult," says Meredith VanAcker, a member of Diuk-Wasser's lab who collected the data as part of her Ph.D. thesis. "And because females don't need to find male mates for reproduction, it is easier for the population to spread."
The threat these new arrivals pose to human health is still unknown. In Asia, there have been reports of ticks passing on a virus that can cause a number of diseases, including hemorrhagic fever and ehrlichiosis, a bacterial illness that can cause flu-like symptoms and lead to serious complications if not treated.
The arrival of the species on Staten Island adds another unwelcome dimension to the region's tick woes, which have grown dramatically in recent years. Thanks to an expanding deer population, Lyme disease spread through deer ticks has reached epidemic proportions in some areas of the Northeast. Deer ticks (also called black-legged ticks) are capable of disseminating six other human pathogens.
The first Asian long-horned tick in the U.S. was identified in New Jersey in 2013. A large population was later found on sheep in Mercer County, New Jersey. Diuk-Wasser became aware of the potential danger when a doctor at a Westchester clinic removed a tick from a patient and sent it in for identification. The discovery of the first human bite prompted widespread alarm.
By then, the Columbia team was already in the midst of an extensive "tick census" on Staten Island to determine how the landscape connectivity between urban parks influenced the spread of disease.
The Asian longhorned is easy to miss because it resembles a rare native species of rabbit tick. VanAcker spent months combing areas of Staten Island for ticks, dragging a square-meter corduroy cloth over leaf litter and examining it every 10 to 20 meters Diuk-Wasser, post-doctoral student Danielle Tufts and other members of the Diuk-Wasser lab found huge numbers of them on the bodies of unconscious deer that had been captured and anesthetized by wildlife authorities.
VanAcker found her collections were overflowing with the new species, leading to publication of the current study in Emerging Infectious Diseases. Her work on landscape connectivity, slated to appear in the June issue of the same journal, drives home the difficult decisions facing policymakers as they attempt to arrest the spread of the new species and others like it.
"The easier it is for deer to maneuver through urban landscapes between parks, the more likely the ticks are to spread to new areas," Diuk-Wasser says. "This suggests that the emphasis on urban wildlife corridors has a previously unappreciated downside for human health."
This study was supported by the Centers for Disease Control and Prevention.
Story Source:
Materials provided by Columbia University. Original written by Adam Piore. Note: Content may be edited for style and length.
Journal Reference:
Danielle M. Tufts, Meredith C. VanAcker, Maria P. Fernandez, Anthony DeNicola, Andrea Egizi, Maria A. Diuk-Wasser. Distribution, Host-Seeking Phenology, and Host and Habitat Associations of Haemaphysalis longicornis Ticks, Staten Island, New York, USA. Emerging Infectious Diseases, 2019; 25 (4): 792 DOI: 10.3201/eid2504.18154
From the May 2017 Wrinkler: DR. JEAN DODDS' PET HEALTH RESOURCE BLOG
![]() TICKS AND TICK-BORNE DISEASES IN DOGS
TICKS AND TICK-BORNE DISEASES IN DOGS
Why is Lyme Disease arguably the most well-known tick-borne disease? One can surmise that the prevalence of Lyme Disease and the regular media coverage about it perpetuates its popularity. Of course, the name is easier to pronounce and remember than the other tick-borne diseases. Instead of talking about the disease first, let’s first categorize the ticks that spread a particular disease or diseases and then follow up with the diseases they cause.
Ticks:
American dog tick (Dermacentor variabilis)
Location: East of the Rocky Mountains and California Coastline
Diseases:
Rocky Mountain Spotted Fever (Rickettsia rickettsii bacterial infection)
Tularemia (Rabbit Fever)
Blacklegged Tick/Deer Tick (Ixodes scapularis)
Location: Upper Midwest, Southeastern, Mid-Atlantic and Northeastern United States
Diseases:
Anaplasmosis – Northeastern and Upper Midwest states
Babesiosis – Northeastern and Upper Midwest
Borrelia mayonii infection – Upper Midwest; particularly Minnesota and Wisconsin
Borrelia miyamotoi infection
Lyme Disease – Northeastern and Upper Midwest states
Powassan Disease – Northeastern and Upper Midwest states; Canada (Northern Ontario)
Brown Dog Tick (Rhipicephalus sanguineus)
Location: Worldwide
Diseases:
Rocky Mountain Spotted Fever – Brown Dog Tick primarily spreads this disease in the Southwestern United States
Ehrlichiosis
Groundhog Tick/Woodchuck Tick (Ixodes cooki)
Location: Eastern United States and Canada
Diseases: Powassan Disease
Gulf Coast Tick (Amblyomma maculatum)
Location: Southeastern United States; primarily along the Gulf and Atlantic Coastlines
Diseases: Rickettsia parkeri rickettsiosis
Lone Star Tick (Ambylomma americanum)
Location: Midwest and Eastern United States. Lone Star Ticks are found in Texas, but are actually named “lone star” because of a single white star-shaped dot on their backs.
Diseases:
Ehrlichiosis – Predominantly Southcentral and Eastern states
Southern Tick-Associated Rash Illness (STARI)
Tularemia (Rabbit Fever)
Heartland Virus Infection
Pacific Coast Tick (Dermacentor occidentalis)
Location: Along the US Pacific Coastline; primarily California
Diseases:
364D Rickettsiosis
Rocky Mountain Spotted Fever
Rocky Mountain Wood Tick (Dermacentor andersoni)
Location: Rocky Mountain States and Southwestern Canada
Diseases:
Rocky Mountain Spotted Fever
Colorado Tick Fever – Fairly isolated to higher elevations
Tularemia (Rabbit Fever)
Soft Ticks
Location: Ornithodoros hermsi tick species – Coniferous forests at altitudes of 1500 to 8000 feet; Ornithodoros parkeri and Ornithodoros turicata species – Southwest United States
Diseases: Tick-Borne Relapsing Fever – Primarily in Western United States
Western Blacklegged Tick (Ixodes Pacificus)
Location: California, Utah, Washington, Oregon, Nevada, Arizona
Diseases:
Anaplasmosis
Lyme Disease – Rare in this region
About diseases:
While acute and initial symptoms vary between each of the diseases, all of them present with practically the same acute, initial flu-like symptoms, such as:
Fever
Lethargy
Inappetence
Swollen Lymph Nodes
Stiffness of the Joints
Diarrhea
Vomiting
Why not call ALL of them “Lyme Disease”? There are several reasons against this classification:
Powassan Disease, Heartland Virus Infection and Colorado Tick Fever are viruses. Note: Powassan virus was first identified in Powassan, Ontario near where I did my veterinary school training in the 1960s! Babesiosis is caused by an intracellular red blood cell parasite. The rest listed above – including Lyme Disease – are all bacterium, and this affects treatment protocols.
The length of time it takes for a tick to transmit a disease. For instance, a tick must be attached for a minimum of five hours to infect a host with Rocky Mountain Spotted Fever.
The length of time for symptoms to present.
If left untreated, chronic conditions of these diseases can manifest differently.
Tick-Borne Bacterial Infections
What is fascinating about the tick-borne bacterial infections is that we treat the majority with doxycycline or minocycline and/or other antibiotics. This is because several of these bacteria are related. Think of them as second or third cousins. However, these bacteria are not related enough to be cross-protected by the Lyme Vaccine. The Lyme Vaccine only covers the bacteria that causes it: Borrelia burgdorferi.
Lyme Vaccine - Yes or No?
Choosing the Lyme Vaccine for your pet needs to be weighed heavily. First, you should consider the documented case risk for Lyme disease in your area. Second, you need to assess the exposure risk imposed by your lifestyle. Even in high-exposure risk areas, I would lean to not automatically vaccinating for Lyme disease, because preventative and treatment measures are easily available and reliable. If relevant clinical symptoms do occur, accurate diagnosis is important. Others have similar views.
University of California Davis Veterinary School of Medicine says:
The incidence of Lyme disease in California is currently considered extremely low. Furthermore, use of the vaccine even in endemic areas (such as the east coast of the US) has been controversial because of anecdotal reports of vaccine-associated adverse events. Most infected dogs show no clinical signs, and the majority of dogs contracting Lyme disease respond to treatment with antimicrobials. Furthermore, prophylaxis may be effectively achieved by preventing exposure to the tick vector. If travel to endemic areas (i.e. the east coast) is anticipated, vaccination with the Lyme subunit or OspC/OspA-containing bivalent bacterin vaccine could be considered, followed by boosters at intervals in line with risk of exposure. The UC Davis VMTH does not stock the Lyme vaccine or recommend it for use in dogs residing solely in northern California.
Ron Schultz of University of Wisconsin School of Veterinary Medicine says:
There may be select areas in the state, “hot spots” where infection is very high and vaccination would be indicated, but dogs in most parts of the state would probably not receive benefit and may actually be at risk of adverse reactions if a large-scale vaccination program was initiated.
For instance, Wisconsin has a much higher risk of Lyme than a state like Maine. However, at our Veterinary Medical Teaching Hospital (VMTH), we have used almost no Lyme vaccine since it was first USDA approved in the early 1990’s. What we have found is infection (not disease), in much of Wisconsin, is low (< 10% infection). As you know, infection does not mean disease. About 3 to 4% of infected dogs develop disease. In contrast, in Western and Northwestern parts of Wisconsin infection occurs in 60 to 90% of all dogs. In those areas, vaccination is of benefit in reducing clinical disease. However, whether vaccination is or is not indicated, all dogs should be treated with the highly effective tick and flea medications available today.
Also, vaccinated dogs can develop disease, as efficacy of the product is about 60 to 70% in preventing disease, thus antibiotics must be used in vaccinated dogs developing disease, just like it must be used in non-vaccinated diseased dogs. Therefore, in general areas with a low infection rate of < 10% infection, the vaccine should not be used – as the vaccine will be of no value and may enhance disease (e.g. arthritis) directly or in some dogs that become infected. In areas where infection rates are high (> 50%) then the vaccine will be very useful.
Based upon these and other expert opinions, it can be considered irresponsible to suggest that all dogs in low-risk exposure states should be vaccinated for Lyme disease. Veterinarians should know, based on diagnoses in their clinic and other clinics in the area (town), how common the disease would be and then should base their judgment to vaccinate upon risk factors, and not on a statement that all dogs in a particular low-risk area need the Lyme vaccine!
W. Jean Dodds, DVM
Hemopet / NutriScan
11561 Salinaz Avenue
Garden Grove, CA 92843
References
“Canine and Feline Vaccination Guidelines.” University of California Davis School of Veterinary Medicine, Nov. 2012. Web. 13 Mar. 2017.
McQuiston, Jennifer, DVM. “Ehrlichiosis and Related Infections.” Merck Veterinary Manual, n.d. Web. 13 Mar. 2017.
“Ticks.” Centers for Disease Control and Prevention, 16 Aug. 2016. Web. 13 Mar. 2017.